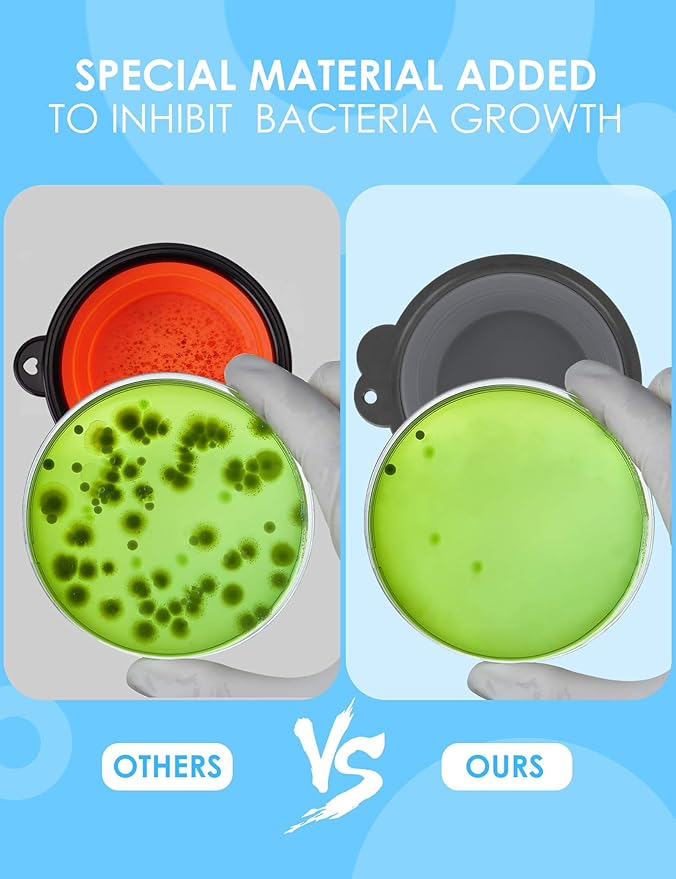
Aonkey Collapsible Dog Bowls with Bottle Carrier, 2 Pack Travel Dog Water Bowl Upgraded Carabiner, One-Piece Molded Rim No Fall Off or Crack, Foldable Silicone Portable for Pets Walking Hiking 37oz

AONKEY
Aonkey Collapsible Dog Bowls with Bottle Carrier, 2 Pack Travel Dog Water Bowl Upgraded Carabiner, One-Piece Molded Rim No Fall Off or Crack, Foldable Silicone Portable for Pets Walking Hiking 37oz
Aonkey Collapsible Dog Bowls with Bottle Carrier, 2 Pack Travel Dog Water Bowl Upgraded Carabiner, One-Piece Molded Rim No Fall Off or Crack, Foldable Silicone Portable for Pets Walking Hiking 37oz
Couldn't load pickup availability
About This
- 【Unique and Different】Aonkey dog bowl set is in a league of its own, addressing issues from feedback on other bowls. The upgraded carabiner boasts a larger, sturdier opening, reducing the risk of breakage. Plus, enjoy the added convenience of bottle carriers, compatible with most cola-shaped water bottles in the market.
- 【Revolutionary Structure】Say goodbye to the hassle of assembled plastic rings. Aonkey's foldable dog bowl boasts an upgraded structure, integrating soft silicone with a hard rim. No more worries about the ring coming off or cracking, and the clip hole remains intact.
- 【Unmatched Stability】Thanks to the integrated hard rim, our dog bowl stays sturdy when unfolded. No more spills or losing structure. Carry it confidently with one hand, even when it's full of water.
- 【Perfect for On-the-Go】These travel bowls are a breeze to pack since they collapse effortlessly. Clip them to a backpack or water bottle – ideal for outgoing to the park, hiking, driving, or any social activities with your furry friend.
- 【Safety First】Crafted from high-quality, food-grade silicone with a tempting beef flavor, our dog foldable bowl eliminates the typical silicone smell that dogs dislike. BPA-free, dishwasher safe, it's not just convenient but also healthy for your pet.
Overview
- Material : Silicone
- Target Species : Dog
- Brand : AONKEY
- Recommended Uses For Product : Hiking
- Special Feature : Collapsible, Food Grade Material, Long-lasting, Portable
Share






you may also like
-

Anxiety Relief for Pets
Provide Comfort and Calm for Anxious Pets with Cozy Companions Co. Anxiety...
-

Cat Travel
Make Traveling with Your Feline Friend Safe and Comfortable with Cozy Companions...
-

Dog Training
Train Your Canine Companion with Confidence and Success using Cozy Companions Co....

Choose everything you want.
Review
-

Chloe⭐⭐⭐⭐⭐
Dog Beds:
"Chloe says: My golden LOVES this bed! So plush and comfy - she snuggles right in. Great quality, worth every penny!"
-

Liam⭐⭐⭐⭐⭐
Dog Food:
"Liam says: My picky pup finally loves a food! Seen a huge difference in his coat & energy. Plus, the ingredients are great. Highly recommend!"
-

Ava⭐⭐⭐⭐⭐
Large Breed Dog Supplies:
"Ava says: As a Dane owner, finding durable products is HARD! This stuff is legit - finally a bed and toys that hold up!"
-

Noah⭐⭐⭐⭐⭐
Cat Litter Boxes:
"Noah says: This litter box is a game-changer! No more scooping as often and keeps the smell at bay. Plus, it looks nice in my bathroom."
-

Sophia⭐⭐⭐⭐⭐
Kitten Starter Kit:
"Sophia says: This kit was a lifesaver when we got our kitten! Had everything we needed to get started. Such a great value!"
-

Oliver⭐⭐⭐⭐⭐
Chew Proof Pet Supplies:
"Oliver says: My lab can destroy anything in minutes...except these toys! Seriously impressed with the durability. A must for chewers!"
Frequently Asked Questions
Yes, we provide free standard shipping on all orders over $100. For orders under $100, a small shipping fee applies, which will be shown at checkout.
If you're not completely satisfied with your purchase, you can return it within 14 for a full refund. Please ensure the item is unused and in its original packaging.
Please contact us at the seller's e-mail at the top of the homepage, and we will handle it immediately upon confirming the details.